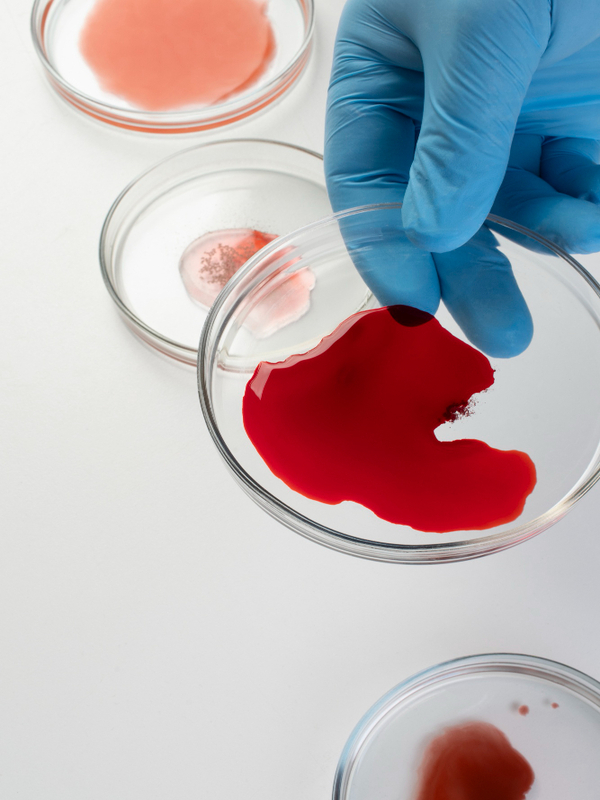

Oncology Services
Providing Oncology Care For The Our Community.
Helping Patients From Around The World
Our Highly Qualified Oncology Team Unparalleled Care.
10
+
Years Of Experience
Oncology Enthusiastically mesh long-term high-impact infrastructures vis-a-vis efficient customer service leadership rather than prospective experiences.
Read More
Caring For The Health And Well Being Of You And Your Family.
At PKDAS Cancer Centre, we are committed to more than just treating cancer—we are dedicated to caring for the overall health and well-being of you and your family. With a focus on personalized care, cutting-edge treatments, and emotional support, our team ensures that every patient receives comprehensive, compassionate care throughout their journey to recovery.
What We Do
Types of Cancer Specialty And Health Care Services
Appointment
Book Your First Appointment
Team Member
Meet Our Specialist And Expert Oncology Doctors
423
+
Successfully Patients
15
+
Doctors And Nurses
425
+
Oncology Cases
10
+